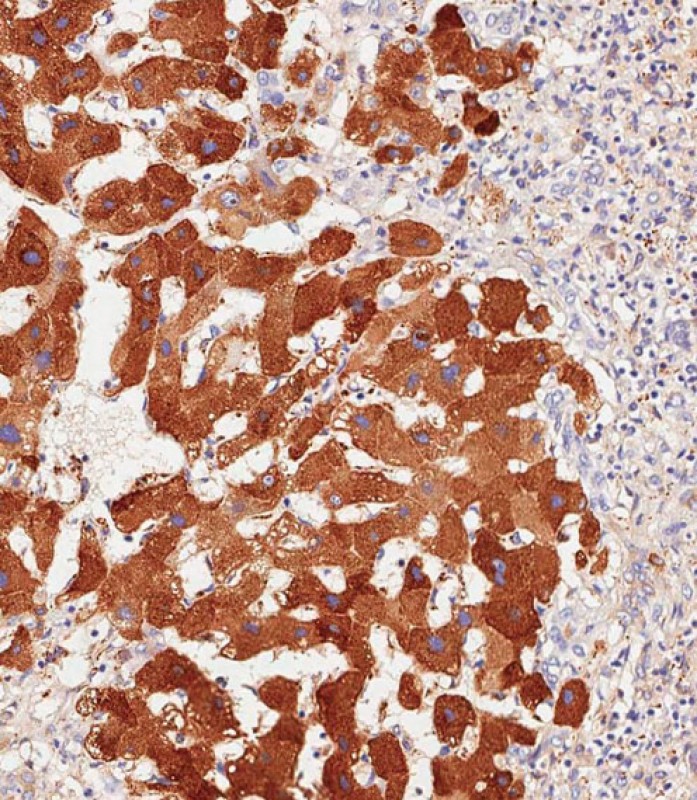

Rabbit Polyclonal Antibody to HP
货号:
P34735
别名:
Haptoglobin, Zonulin, Haptoglobin alpha chain, Haptoglobin beta chain, HP
应用:
WB,IHC
反应种属:
Human, Mouse, Rat
抗体类型:
Primary antibody
Swissprot:
P00738
规格:
目录价
在线咨询
Description |
|---|
This gene encodes a preproprotein, which is processed to yield both alpha and beta chains, which subsequently combine as a tetramer to produce haptoglobin. Haptoglobin functions to bind free plasma hemoglobin, which allows degradative enzymes to gain access to the hemoglobin, while at the same time preventing loss of iron through the kidneys and protecting the kidneys from damage by hemoglobin. Mutations in this gene and/or its regulatory regions cause ahaptoglobinemia or hypohaptoglobinemia. This gene has also been linked to diabetic nephropathy, the incidence of coronary artery disease in type 1 diabetes, Crohn's disease, inflammatory disease behavior, primary sclerosing cholangitis, susceptibility to idiopathic Parkinson's disease, and a reduced incidence of Plasmodium falciparum malaria. A similar duplicated gene is located next to this gene on chromosome 16. Multiple transcript variants encoding different isoforms have been found for this gene. |
Specification |
|
|---|---|
| Aliases | Haptoglobin, Zonulin, Haptoglobin alpha chain, Haptoglobin beta chain, HP |
| Entrez GeneID | 3240 |
| Swissprot | P00738 |
| WB Predicted band size | 45.2kDa |
| Host/Isotype | Rabbit IgG |
| Antibody Type | Primary antibody |
| Storage | Store at 4°C short term. Aliquot and store at -20°C long term. Avoid freeze/thaw cycles. |
| Species Reactivity | Human, Mouse, Rat |
| Immunogen | This HP antibody is generated from rabbits immunized with a KLH conjugated synthetic peptide between 296-322 amino acids from the Central region of human HP. |
| Formulation | Purified antibody in PBS with 0.05% sodium azide. |
Application |
|
|---|---|
| WB | 1/1000 |
| IHC | 1/500 |
Product Image
-
Anti-HP Antibody (Center) at 1:2000 dilution + Human plasma lysate Lysates/proteins at 20 µg per lane. Secondary Goat Anti-Rabbit IgG, (H+L), Peroxidase conjugated at 1/10000 dilution. Predicted band size : 45 kDa Blocking/Dilution buffer: 5% NFDM/TBST.

-
Immunohistochemical analysis of paraffin-embedded Human hepatocarcinoma tissue using P34735 performed on the Leica® BOND RXm. Tissue was fixed with formaldehyde at room temperature, antigen retrieval was by heat mediation with a EDTA buffer (pH9. 0). Samples were incubated with primary antibody(1:500) for 1 hours at room temperature. A undiluted biotinylated CRF Anti-Polyvalent HRP Polymer antibody was used as the secondary antibody.

-
Immunohistochemical analysis of paraffin-embedded Human hepatocarcinoma tissue using P34735 performed on the Leica® BOND RXm. Tissue was fixed with formaldehyde at room temperature, antigen retrieval was by heat mediation with a EDTA buffer (pH9. 0). Samples were incubated with primary antibody(1:500) for 1 hours at room temperature. A undiluted biotinylated CRF Anti-Polyvalent HRP Polymer antibody was used as the secondary antibody.

-
Immunohistochemical analysis of paraffin-embedded Human colon tissue using P34735 performed on the Leica® BOND RXm. Tissue was fixed with formaldehyde at room temperature, antigen retrieval was by heat mediation with a EDTA buffer (pH9. 0). Samples were incubated with primary antibody(1:500) for 1 hours at room temperature. A undiluted biotinylated CRF Anti-Polyvalent HRP Polymer antibody was used as the secondary antibody.

-
Immunohistochemical analysis of paraffin-embedded Human hepatocarcinoma tissue using P34735 performed on the Leica® BOND RXm. Tissue was fixed with formaldehyde at room temperature, antigen retrieval was by heat mediation with a EDTA buffer (pH9. 0). Samples were incubated with primary antibody(1:500) for 1 hours at room temperature. A undiluted biotinylated CRF Anti-Polyvalent HRP Polymer antibody was used as the secondary antibody.

鄂公网安备42018502007531号

